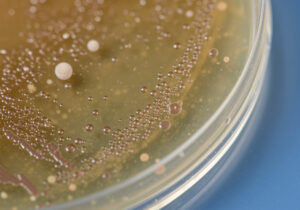
Microorganismos patógenos

General
Microorganismos patógenos: medidas de bioseguridad para evitar contagios
Los microorganismos patógenos (bacterias, virus, hongos, parásitos…) pueden causar infecciones graves si no se manejan correctamente en laboratorios, instalaciones sanitarias o entornos industriales sensibles.